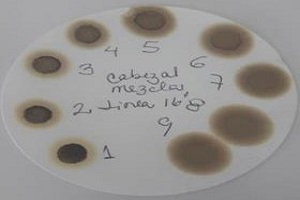
Image placeholder

SERVICIOS - PRODUCCION
Limpieza / Desplazamiento "Surface"
- Líneas de flujo
- Múltiples de Producción
- Pozos - Cabezales
Limpiezas / Estimulaciones "Dowhole"
- No reactivas
- Reactivas
- Matriciales
- No Fracking

SERVICIOS - PRODUCCION
Instalación de tubería capilar en:
- Pozoz Verticales
- Desviados /Hrizontales
Productos Aplicados Downhole:
- Dispersantes de Asfalténos / Parafinas
- Mejoradores de flujo
- Dispersante de Incrustaciones
- Rompedores de Emusión
- Espumantes
UAP HT 400
Unidad de Alta Presión HT 400, dicha unidad operar hasta las 20,000 psi (1379 bar) de presión y bombear a tasas de inyección hasta los 19 barriles por minuto (3 m3 por minuto). La bomba de la HT-400 pump posee una potencia nominal de 800 caballos de fuerza hidráulicos (hhp).

Aplicación:
- Limpiezas
- Estimulaciones
- Cementaciones
- Forzamiento de Cemento (Squeeze)
- Abandono de pozos
- Empaque con Gravas
- Fracturamiento hidráulico
- Desplazamiento de líneas de flujo, cabezales, etc
- Bombeo de transferencia.
- Inyección de Geles aislantes
- Pruebas de integridad de presiones anormales.
- Tapones de arena
- Pruebas hidrostáticas de alta presión
- Pruebas de Inyectividad
SERVICIOS DE LABORATORIO

- Diseño de sistemas de tratamiento para estimulaciones
- Reactivas y No reactivas
- Formulaciones para limpiezas de depósitos de material orgánico e inorgánico en tubulares o vecindad del yacimiento
- Contenido de Agua, Emulsión y Sedimentos
- Pruebas de dispersión de asfalténos
- Caracterización de Aceites
- Contenido de Asfalténos y Parafinas
- Pruebas de Botellas
- Pruebas de Selección de espumantes
- Perfiles de Viscosidades dinámicas
- Evaluación de Desemulsificantes
- Pruebas de compatibilidad química con aceite/agua
- Análisis de Inhibidores de asfalténos y parafinas
- Análisis fisicoquímicos de agua